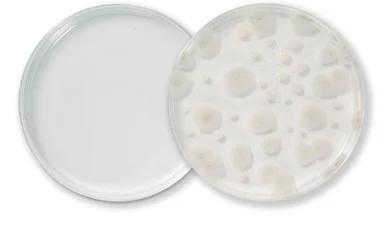
محیط کشت CZA
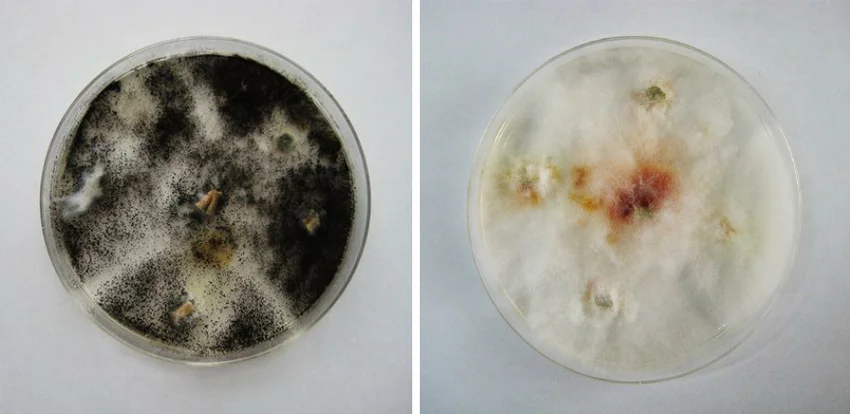
تفسیر نتایج زاپکس آگار

مقدمهای بر زاپکس آگار
- محیط کشت زاپکس، همچنین به نام زاپکس آگار یا زاپکس داکس (Czapek-Dox)، یک محیط رشد برای تکثیر قارچها و سایر ارگانیسمها در آزمایشگاه است.
- این محیط همچنین برای استفاده در روشهای کیفی جهت کشت قارچهای ساپروفیت (دوستدار مواد گندیده یا Saprophytic)، باکتریهای خاک و سایر میکروارگانیسمها توصیه شده است.
- این محیط در ابتدا توسط Czapek در سال 1902 برای کشت قارچهای ساپروفیت معرفی شد.
- آگار زاپکس داکس با اصلاح فرمول آگار Czapek (1902-1903) و Dox (1910) توسط Thom و Church تهیه شده است. این محیط حاوی ساکارز (Sucrose) به عنوان تنها منبع کربن و نیترات به عنوان تنها منبع نیتروژن غیرآلی میباشد.
ترکیبات آگار زاپکس آگار
| ترکیبات | گرم در لیتر |
| ساکارز | 30 |
| نیترات سدیم (Sodium nitrate) | 2 |
| دیپتاسیم فسفات (Dipotassium phosphate) | 1 |
| سولفات منیزیم (Magnesium sulfate) | 0.5 |
| کلرید پتاسیم (Potassium chloride) | 0.5 |
| فروس سولفات (Ferrous sulfate) | 0.01 |
| آگار | 15 |
pH نهایی (در دمای 25 درجه سانتیگراد): 0.2±7.3
اصول محیط کشت CZA
محیط کشت زاپکس یک محیط جامد و خنثی بوده که حاوی نیترات سدیم به عنوان تنها منبع نیتروژن میباشد. قارچها و باکتریهایی که قادر به استفاده از این منبع نیتروژن غیرآلی هستند، در این محیط رشد خواهند کرد. ساکارز منبع انرژی و تنها منبع کربن، دیپتاسیم فسفات یک عامل بافر، کلرید پتاسیم حاوی یونهای ضروری و سولفات منیزیم و سولفات آهن منابع کاتیونها (Cation) هستند.
آماده سازی و روش استفاده از زاپکس آگار
- 01 گرم از زاپکس آگار را در 1000 میلیلیتر آب مقطر بریزید.
- آن را حرارت داده تا به جوش آید و محیط کاملا حل شود.
- محیط را با قرار دادن در اتوکلاو با فشار 15 پوند (121 درجه سانتیگراد) به مدت 15 دقیقه استریل کنید.
- محیط را تا دمای 45 تا 50 درجه سانتیگراد خنک کنید.
- آن را خوب مخلوط کرده و در پلیتهای پتری (Petri plate) استریل بریزید.
- ارگانیسم را برای آزمایش با پخش کردن نمونه روی سطح محیط آگار به صورت لایهای نازک، تلقیح کنید.
- محیط را به صورت هوازی در دمای 25 تا 30 درجه سانتیگراد به مدت 1 تا 2 هفته، انکوبه کنید.
- پلیت را برای بررسی رشد ارگانیسم، در فواصل منظم بررسی کنید.
- هر نوع کلنی را در محیطهای مناسب برای ایزولاسیون زیرکشت دهید. کلنیها را طبق روشهای آزمایشگاهی تعیین شده شناسایی کنید.
روش لوله آزمایش: آگار موجود در لوله آزمایش را در یک حمام آب (Water bath) در حال جوش ذوب کرده و تا دمای 45 تا 50 درجه سانتیگراد خنک کنید. سپس آن را مخلوط کرده و در پتری دیش استریل بریزید و طبق دستورالعمل بالا ادامه دهید.
تفسیر نتیجه زاپکس آگار
| ارگانیسم | رشد |
| آسپرژیلوس برازیلینسیس (Aspergillus brasiliensis) | رشد خوب |
| کاندیدا آلبیکنس (Candida albicans) | رشد خوب؛ کلونیهای کرم رنگ |
| ساکارومایسس سرویزیه (Saccharomyces cerevisiae) | رشد خوب |
| آسپرژیلوس نیجر (Aspergillus niger) | میسلیوم (Mycelium) سفید یا زرد، اسپورهای (Spore) سیاه |
موارد استفاده از زاپکس آگار
- زاپکس داکس آگار توسط انجمن داروسازی آمریکا (APHA) برای جداسازی آسپرژیلوس (Aspergillus)، پنیسیلیوم (Penicillium)، پسیلومایسس (Paecilomyces) و برخی قارچهای دیگر با نیازهای فیزیولوژیکی مشابه توصیه شده است.
- محیط کشت زاپکس در روشهای استاندارد بررسی آب و فاضلاب برای جداسازی آسپرژیلوس، پنیسیلیوم و قارچهای مرتبط توصیه میشود.
- این محیط به طور گسترده برای مطالعات تاکسونومی (Taxonomy) پنیسیلیوم استفاده میشود.
- زاپکس آگار تقریباً در تمام قارچهای آسپرژیل ساپروفیت، رشد شدیدی ایجاد میکند و میسلیوم (Mycelium) و کنیدیوم (Conidium) تولید میکند.
- اسیدیته محیط میتواند برای کشت ارگانیسمهای اسیدوفیل (Acidophilic) مانند مخمرها، افزایش یابد.
- این محیط در انواع تستهای میکروبیولوژیکی، از جمله آزمایشهای مقاومت قارچها و کپکها و آزمایشهای میکروبیولوژی خاک مفید است.
محدودیت های محیط کشت CZA
- این محیط کشت یک محیط عمومی است و ممکن است از رشد ارگانیسمهای سختپسند (Fastidious) پشتیبانی نکند.
- توصیه میشود برای شناسایی کامل، آزمایشات بیوشیمیایی، ایمونولوژیک، مولکولی یا طیف سنجی جرمی روی کلنیهای حاصل از کشت خالص انجام شود.
جهت خرید و یا استعلام قیمت با ما تماس بگیرید یا در واتسپ پیام بزارید
مطالب مرتبط:
- تست PYR: اصول، کاربردها، روش و تفسیر نتایج
- محیط کشت DCA: ترکیب، اصول، روش آمادهسازی، نتایج و کاربرد
- محیط کشت BSA: ترکیب، اصول، آمادهسازی، نتایج و کاربرد
مترجم: صادق حسینیکیا